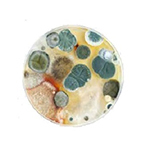

ПРОФЕССИОНАЛЬНАЯ ДЕЗИНФЕКЦИЯ
от 500 руб в Свердловской области

Избавляем с первого раза от насекомых, грызунов, вирусов, плесени и запаха в 98% случаев

Гарантия результата до 36 месяцев по договору

Препараты БЕЗ ЗАПАХА
Безопасно для людей, животных и растений
Безопасно для людей, животных и растений
Узнайте стоимость дезинфекции вашего объекта по телефону:
Нажимая на кнопку "Узнать стоимость", я соглашаюсь на обработку моих персональных данных и ознакомлен(а) с Политикой конфиденциальности
Скидка 10% при оформлении заявки через сайт
ПОЛНЫЙ КОМПЛЕКС УСЛУГ ПО ДЕЗИНФЕКЦИИ
БЕЗОПАСНО ДЛЯ ЛЮДЕЙ, ЖИВОТНЫХ И РАСТЕНИЙ

Препараты низкого класса опасности
Используем сертифицированные средства 4-го класса опасности

Специальная подготовка объекта
Защита продуктов питания, личных вещей, детских игрушек и прочего имущества от попадания препаратов

Вернуться можно уже через 3 часа
Помещение готово к использованию после проветривания и уборки
Частные помещения
Частные дома, квартиры, гаражи
Коммерческие объекты
Склады и хранилища, производства
Детские организации
Сады, школы, секции, игровые комнаты
Общественные объекты
Магазины, общепит, салоны красоты, медицинские центры, спортивные комплексы, гостиницы
Открытые территории
Сельскохозяйственные поля, придомовые территории и участки
РАБОТАЕМ СО ВСЕМИ ТИПАМИ ОБЪЕКТОВ

Тараканов
Избавляем от

Клопов

Муравьев

Клещей

Комаров

Короедов

Двухвосток

Мокриц

Моль

Блох

Ос

Мух

Неприятного запаха

Вирусов
Плесени

Крыс


Кротов
Мышей





ПОЛУЧИТЕ СКИДКУ ДО 10% НА ДЕЗИНФЕКЦИЮ
Сэкономьте время нашего менеджера, ответив на 5 вопросов
ПОСМОТРИТЕ, КАК МЫ РАБОТАЕМ
Опыт с 2015 года
Более 10000 клиентов
Гарантия 36 месяцев
Проводим качественную дезинсекцию более 7 лет
Большой опыт работы с частными и коммерческими объектами
Даем расширенную гарантию до 36 месяцев по договору
КРУПНЫЕ КОМПАНИИ ЗАКАЗЫВАЮТ ДЕЗИНСЕКЦИЮ У НАС


















ПРОЧИТАЙТЕ ОТЗЫВЫ НАШИХ КЛИЕНТОВ
ОСТАЛИСЬ ВОПРОСЫ?
Или у вас особый случай, и стандартные решения не подходят?

Кристина
Закажите бесплатную консультацию специалиста
Нажимая на кнопку "Узнать стоимость", я соглашаюсь на обработку моих персональных данных и ознакомлен(а) с Политикой конфиденциальности
Старший менеджер


